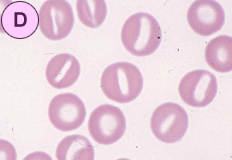

Q14. 赤血球の形態所見を下記より選んで下さい。 解答と解説
![]() |
![]() |
|
|---|---|---|
![]() |
![]() |
|
| 選択細胞 | |
| 1 | 正常 normal |
|---|---|
| 2 | 有口赤血球 stomatocyte |
| 3 | 標的赤血球 codocyte |
| 4 | 楕円赤血球 elliptocyte |
| 5 | 人工産物 artifact |
【ねらいと解説】
今回も末梢血の赤血球形態の形状変化を提示しました。
A. は赤血球の輪郭が円形のものと卵円形(oval)ないし棒状(rod shaped)がみられ、前者は正常赤血球で後者は楕円赤血球(elliptocyte)とよばれます。通常、大球性貧血の症候性楕円赤血球症でみられますが、遺伝性疾患の遺伝性楕円赤血球症では90%以上みられるそうです。この変形は成熟赤血球になった後に生じる変化とされ細胞骨格を形成するタンパク質が関与しているようです。考えられる病態は溶血性貧血ですが、この場合楕円赤血球の他に種々の奇形赤血球を認める場合に限定され、網赤血球増加の有無や血清ビリルビン値(間接型)、脾腫など溶血に関する検査を進めることになります。
B. は偽楕円赤血球の出現です。塗抹の際のアーテイファクトですが、一定の方向に向いていることがポイントになります。
C. は標的赤血球(codocyte)です。“codo”はギリシャ語でベル(bell)を意味するそうで、codocyteはベル状や円形ドーム型の赤血球といわれています。Hbが中央では小山をなし周辺部で環状に分布するため、標的(target)やメキシコ帽子(Mexican hat)にたとえられる形態異常です。赤血球の表面積が増加するとコレステロールが挿入されて膜過剰が生じ、一方Hb合成が障害されると体積が減少し、相対的に表面積過剰となり、codocyteに変形するといわれています。
D. は赤血球の中央淡明部が長方形に変形し、赤血球は唇をわずかに開いて白い歯をのぞかせる口のようにみえるため、有口赤血球(stomatocyte)とよばれます。Cup-shaped cellともよばれ機序は明確でありませんが、血球内の陽イオン濃度の変化(Naの増加、カリウムの減少)といわれています。遺伝性溶血性貧血、Rh null 症候群、アルコール性肝障害などでみられるようです。
(参考文献:A,D,E; 松本昇:ベーシック形態検査.医歯薬出版.1988)
【解答】
A: 4.楕円赤血球
B: 5.人工産物
C: 3.標的赤血球
D: 2.有口赤血球
【正解率】
A: 100%
B: 90%
C: 100%
D: 90%
形態マガジンTOPへ戻る
「症例14 解答と解説 」 を見る→